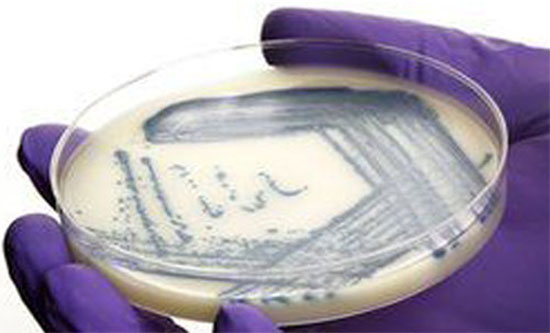

Over the past 41 years, our mission has been to contemporize the science behind traditional medicine and develop products
that are safe and effective. With a production capacity exceeding 1 million tablets, 10,000 tubes and 10,000 bottles per
day,
Unexo remains committed to providing the best in class healthcare solutions. Our in-house quality control
department
performs composition and shelf life conformance tests on every batch to ensure our customers
receive safe
and effective medicines.
Our in-house R&D team scouts for new innovations in medical
healthcare across the world and strives to
continuously bring
our formulations that are more potent and safe. We have
been introducing a new
product or a variant an average
of every 6 months based on new reported
findings,
clinical trials and market surveys.
Our current research focuses on improving the
extraction yield
from therapeutic plants
and herbs to formulate more
potent
and patient compliant doses.
Copyright 2013 Unexo Laboratories Pvt. Ltd. All Rights Reserved. Designed & Developed By: Credence Technologies



